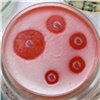
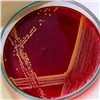

Эксперты Красноярского государственного медицинского университета изучают, как пахнут различные бактерии. Об этом рассказала заведующая кафедрой микробиологии КрасГМУ Елена Бочанова, пишет краевой Минздрав.
Как отмечают специалисты, некоторые опасные бактерии обладают приятными ароматами. Синегнойная палочка, способная вызывать тяжелые инфекции, пахнет жасмином или карамелью. Грибы рода Candida, провоцирующие молочницу, имеют аромат свежей выпечки.
Среди менее приятных примеров — гемофильная палочка, которая пахнет мокрой шерстью, и молочнокислые бактерии с аммиачным запахом. Кишечная палочка, как и ожидается, имеет характерный фекальный запах.
Важно понимать, что обнаружение подобных запахов в обычной жизни не свидетельствует о наличии опасных бактерий — эти характеристики проявляются только в лабораторных условиях при выращивании культур.